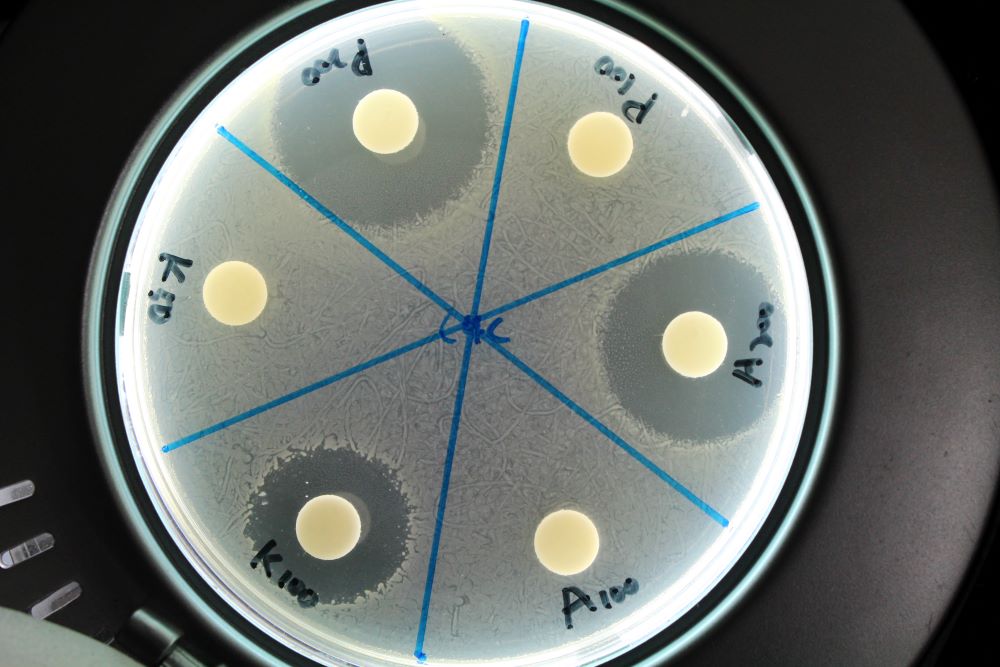

寵物常用乳酸菌種類介紹
乳酸菌的應用由來已久,自數千年前,就被應用在各種發酵食物上,例如乳酪、泡菜、臭豆腐等產物,當然古早的人們只知其然而不知其所以然,直到科學的興起,才在1857年由細菌學之父巴斯德發現乳酸菌存在於這些發酵食品中,往後經過多年的研究,人們漸漸了解到乳酸菌對人體的益處,到了1930年,日本科學家代田稔第一次將乳酸桿菌(Lactobacillus casei)分離純化出來,也就是養樂多的主要菌種代田菌,自此之後,各種乳酸菌相繼被發現及應用,其中也包括寵物用的乳酸菌,從人吃的乳酸菌開始,漸漸發展成各種不同禽畜源,或有特殊功能(抗敏、抗緊迫、抗病、減重、抗發炎、甚至保護關節、保護肝腎等...)的專用乳酸菌產品,不僅提升寵物的健康與福祉,也讓飼育更為得心應手不過乳酸菌(Lactic acid bacteria)跟硝化菌一樣,指的都不是單一菌株,而是一群具有特定能力的菌,它可以是桿菌或(鏈)球菌,具有以下共同的生理生化特性(Kander and Weiss, 1986):
1. 革蘭氏陽性菌
2. 能代謝碳源並產生乳酸(50%以上)
3. 不具catalase與cytochrome
4. 不會產生硫化氫及indole
5. 不具運動性
6. 不會產生內孢子
7. 一般為厭氧或兼性厭氧
雖然原本學術上的定義如此,但隨著相關研究越來越多,一些原則也出現例外(例如Sporolactobacillus屬既會產生孢子也具有運動性),且商業上只要是會產生乳酸的益生菌,甚至是能幫助消化的益生菌,都有可能被泛稱為乳酸菌(例如Bacillus coagulans),尤其是規範較為鬆散的寵物市場,更甚者,也有直接將消化酵素包裝成乳酸菌產品的,因此在選擇產品時,清楚理解成分內容,相當重要

乳酸菌會產酸(以乳酸為主)是其一大特徵
近年來隨著微生物學的發展,目前被普遍認定的乳酸菌已由早期的四個屬增加到17個屬,其中較常用作寵物添加劑的有以下幾屬:
Lactobacillus sp. (乳桿菌屬)
目前在動物身上使用最多的菌屬,被研究的菌種相當多,包括:
嗜酸乳桿菌(L. acidophilus) - 多半在腸胃道被發現,產酸能力強,能維持消化道環境,並能分泌抑菌素,抑制多種病原(包括大腸桿菌、沙門氏菌等...)
植物乳桿菌(L. plantarum) - 大多在發酵植物性食品上被發現,如豆干、泡菜等,能有效刺激免疫反應,並減緩發炎反應,提升免疫力
醱酵乳桿菌(L. fermentum) - 耐酸性高,能減少壞菌孳生,改善發炎情形
鼠李糖乳桿菌(L. rhamnosus) - 平衡與改善胃腸道功能、 增強自身免疫能力、還能減緩腹瀉及過敏反應
副乾酪乳桿菌(L. paracasei) - 有效刺激免疫反應,提升免疫力
許多乳酸菌都有抑制病原的能力
Pediococcus sp. (片球菌屬)
本屬的菌常存在於蔬菜與動物、食品與發酵飲料中,是消化道中的常態菌群,友浚使用的戊糖片球菌(P. pentosaceus)是由台大及澎科大團隊由海鱺魚腸道分離出的魚源乳酸菌,不僅是最適合魚類的乳酸菌,還能抑制許多病原菌,包括發光桿菌、副溶血弧菌、鰻弧菌等...,有效降低魚隻死亡率,並提升魚隻病原抵抗力、生長率及吞噬細胞活性(提升免疫力),增進生理健康,且後續研究表示對不同魚種同樣有效

P. pentosaceus對其他魚種同樣有促進健康的效果
Streptococcus sp. (鏈球菌屬)
代表性菌種為嗜熱鏈球菌(S. thermophilus),不僅耐熱,對胃酸及膽鹼耐受力強,相當適合製作食品,因此被廣泛應用在發酵乳製品,如優酪乳及乳酪,當然也可以提供禽畜使用,其能幫助乳糖消化、增強腸道屏障、促進腸道好菌產生代謝物質、產生胞外多醣提升保護力,是相當稱職的輔助角色
Enterococcus sp. (腸球菌屬)
由於有部分的腸球菌為機會感染菌,具有安全疑慮,所以本屬菌一直不為寵物市場所待見(通常會以雙岐桿菌取代),但他卻是應用最為廣泛的乳酸菌種類之一(Patterson and Burkholder, 2003),代表物種為屎腸球菌(E. faecium),只要確認其安全性,腸球菌也具有難以取代的好處,由於生長速度快,競爭附著腸道上皮細胞的效率是一般乳酸菌的3倍,能快速競爭排除病原,並產生有機酸或是抑菌物質,競爭排除或調節免疫來改善菌相平衡 (Wageha et al., 2008),協助維持菌群正常生態,維持宿主腸道健康
Bifidobacterium sp. (雙岐桿菌屬)
人體腸道益生菌的代表,可在包括人在內的哺乳動物體內發現,較為知名的有比菲德氏菌(B. bifidum)、龍根菌(B. longum)等...是人體內數量最多的優勢菌種,且會隨著年齡漸漸減少,部分種類也被用在犬貓,例如乳雙岐桿菌或稱動物雙岐桿菌(B. animalis),因其在腸道中與腸黏膜上皮細胞吸附力強,可以快速形成優勢、維持腸道菌叢平衡及幫助消化
其他還有Leuconostoc sp.、Sporolactobacillus sp.、Lactococcus sp.、Carnobacterium sp.、Weissella sp.等屬,甚至Bacillus coagulans、Bacillus subtilis也會使用在乳酸菌產品中,雖然種類眾多,但相關研究仍以人體為主,而不同動物由於體溫及消化系統不同,人用的乳酸菌不見得適合寵物,尤其是親緣關係更遠的鳥類、兩爬甚至魚蝦,因此友浚在選擇益生菌種類時,除了確保菌種皆有相關研究,適用於對應的物種之外,也會儘量挑選同物種來源的乳酸菌,這樣才能讓乳酸菌發揮最佳作用,而不會有不適的情況產生
乳酸菌固然有許多優點,但在使用上也有其限制,由於大多數的乳酸菌都不含內孢子,因此在製劑或保存上會有困難,不過隨著科技的進步,要將活菌製成粉末也不無可能,加上乳酸菌在培養上的特點,他能培養到非常高的濃度,一般菌養到8~9次方就很難再提高,而乳酸菌甚至能養到培養基濃濃稠稠,高達11~12次方,高菌量意味著在製劑的過程中雖然大部分的菌會耗損,但只要少數比例能存活,數量還是很可觀,而且乳酸菌還有個過人之處,其許多有效成分源自代謝產物,因此就算是死菌,也有一定的效果,活菌當然好,效果也更持久,但其實只要調整劑量與使用方法,死菌產品效果一樣不差,而且死菌產品還能額外添加許多營養素,反而更受歡迎,另外,乳酸菌在作為飼料添加時,建議是即混即用,除非是要做發酵飼料,平時保存時務必保持乾燥,能冷藏更好,若產品或混和的飼料結塊,就不建議再使用了,添加劑很營養,但希望此營養能完整保留給寵物而不是滋生雜菌,否則就本末倒置了




